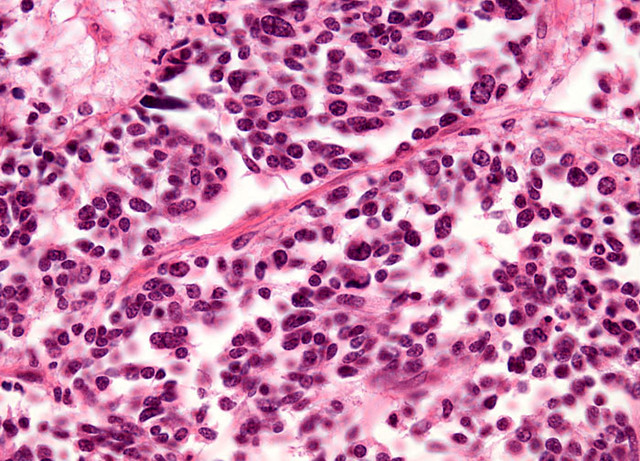
The Diagnoses

-
During the winter of 1964, "Hassan's mother, Sanaubar, gave birth to him" (Hoseini 6) in the small shack that would soon be his home. Hassan is one of the most developed characters in the story, and his relationship with Amir creates the plot. With this introduction that foreshadows Hassan's life, it allows for readers to follow Hassan's growth throughout the story and see how he has changed in his actions and behaviors.
-
-
During Amir and Hassan's daily session of reading, Amir decides to play a trick on Hassan, who is illiterate, by "abandon[ing] the text altogether...and made up his own" (Hosseini 30). Hassan surprisingly begins to clap and says that that story was the best one yet. This is an event that encouraged Amir to pursue his passion for writing. Even though Baba discourages it and wishes Amir would take up more masculine careers, Amir still holds his desire to become a writer after Hassan's inspiration.
-
Every winter, a kite flying competition occurs in the Afghan neighborhoods. Hassan is exceptional at reading where the kite will land, but "In the winter of 1975, [Amir] saw Hassan run a kite for the last time" (Hosseini 55). Assef takes advantage of Hassan when he goes to retrieve the kite to make Hassan feel below him because of his Hazara background. Amir witnesses Hassan being raped by Assef and doesn't step in to help. This changes the way he views himself and their friendship from then on.
-
With Amir's thirteenth birthday also came the end of his and Hassan's friendship. Amir plants his birthday gifts under Hassan's bed to inflict guilt onto him, but Hassan accepts the blame which Amir soon understands that it was "Hassan's final sacrifice for [him]" (Hosseini 105). Through this sacrifice, it is clear that Hassan truly cares about Amir and will do anything to protect him. Amir is jealous of the way Hassan won't ever retaliate and takes this opportunity to release his guilt.
-
The first Soviet troops in the invasion of Afghanistan in 1979 "parachuted into Kabul on Dec. 27, 1979, to assist Babrak Karmal, who had become president in a coup within the Afghan Communist leadership" (New York Times 2). The country then falls into chaos of violence and war.
-
As the war escalates around Amir and Baba, it's no longer safe to be residing in Kabul. Citizens no longer trusted one another because "even at the dinner table, in the privacy of their home, people had to speak in a calculated manner" (Hosseini 113). As a result of this, Baba and Amir escaped during one night in March to Jalalabad. With bad luck, the truck for their final leg of the trip broke down, and they were stuck for quite a while. During this time, Amir was able to witness Baba's morals.
-
Once Baba and Amir were able to escape their chaotic homeland and arrive in America, Amir revisits his education again. In 1983, he "graduated from high school at the age of twenty, by far the oldest senior..." (Hosseini 131). His graduation marked the end of an innocent boy, and instead his rite of passage into adulthood. Graduation led to his opening to college where he soon pursued his dreams of becoming a writer; it also bonded him to Baba because Baba soon accepted Amir for who he was.
-
A year after Baba and Amir begin to settle in America, they being a weekly activity that consisted of selling items at a flea market for a small profit; in fact, "by that summer, Afghan families were working an entire section of the San Jose flea market" (Hosseini 137). This event is significant in that it shows how their Afghan backgrounds were still carried with them into America. This is also the place where Amir meets Soraya, his soon-to-be wife.
-
Unfortunately, with Baba's age and smoking habits, he was diagnosed with a form of lung cancer, "Oat Cell Carcinoma"
(Hosseini 156) in 1984. Through this experience, Amir was able to see how much society and even distant friends respected Baba because many of them came to visit as his health gradually deteriorated. It also signified the beginning of Amir's independence and responsibility for his own actions now that Baba is incapable of writing out what Amir can and cannot do. -
By the year of 1985, six years after the Soviet invasion, "half of Afghan population [is] now estimated to be displaced by war, with many fleeing to neighbouring Iran or Pakistan" (BBC).
-
Just as Baba is fading away with his deteriorating health due to cancer, Amir asks him for one final thing which is to ask for Soraya's hand in marriage. He agrees and in 1986, Amir "walk[s] toward the stage, now in my tuxedo, Soraya a veiled pari in white, our hands locked" (Hosseini 170). This moment is when Amir is now capable of making his own decisions since he was the one who initiated to ask Soraya for marriage. It is also his symbol of independence.
-
To fulfill his lifelong goal of becoming a successful writer, Amir finally completes his first novel about "a father-son story set in Kabul, written mostly with the typewriter the general had given me" (Hosseini 182) and is accepted by a New York agency for his work. This event in the story portrays how with hard work and determination comes success. He had always wanted to be a writer, despite Baba's discontent, and he ultimately proves him wrong by successfully writing his first novel.
-
In February of 1989, the Soviet troops left Afghanistan which "was not only devastated by the war but that had become a beacon to Islamic extremists from across the globe...including Osama bin Laden" (New York Times 2).
-
Twenty-six years after eloping with a gypsy tribe, Sanaubar returns "to see if [Hassan] was as beautiful in the flesh as [he] was in [her] dreams" (Hosseini 210). She returns just in time to deliver Hassan's son, Sohrab. Her return symbolizes a new beginning for the characters in the story, as life changes drastically for Hassan. Sanaubar becomes a second motherly figure for Sohrab, and the two grow inseparable.
-
A new group "dedicated to purifying the country" was formed by a student movement, and the leader, Mullah Omar "had nearly 12,000 followers" (New York Times 2) by 1994; the movement became highly popular with its use of brutality.
-
With support from Pakistan, the Taliban "had taken control of Afghanistan, imposing strict enforcement of fundamentalist Islamic law, banning movies and music and forcing women out of school" (New York Times 3) by 1996.
-
With the new Taliban government ruling Afghanistan, not only were kite tournaments banned, but also in 1998, "they massacred the Hazaras in Mazar-i-Sharif" (Hosseini 213). With this violent form of repression of this ethnic tribe, Hassan and his family become major targets. They can no longer live without the fear of being shot for the Taliban were ruthless when it came to evicting the Shias. This event foreshadows the fate Hassan and Fazara soon have ahead of them.
-
In 2001, the former Afghan king, Hamid Karzai "was named chairman of an interim government that replaced the defeated Taliban," and a couple years later, he was "elected to a five-year term as president in 2004" (New York Times 3) to ultimately bring back stability to the country.
-
After a long journey to bring Sohrab to the U.S, Amir and Sohrab finally "arrived home about seven months ago, on a warm day in August 2001" (Hosseini 357). His return to America represents a fresh new start for Sohrab. It is a chance at a new life for Sohrab to start over again after a scarring childhood. This event is also a time for Amir to see Soraya which brought a flood of emotions and joy for them.
-
On September 11th of 2001, the World Trade Center was bombed, led by the Al Qaeda and their leader, Osama bin Laden. As a result, President Bush gave the Taliban one final chance to hand over their leader, and when refused, "the United States joined forces with rebel groups" and "an air and ground campaign began that drove the Taliban out of the major Afghan cities by the end of the year" (New York Times 3).
-
During Amir's journey to retrieve Sohrab, he visits a soccer match in order to speak with the Talib holding Sohrab. Unknowingly, the half-time exhibition for the match consisted of a "Talib looking absurdly like a baseball pitcher on the mound, hurdl[ing] the stone at the blindfolded man in the hole" (Hosseini 271) until the man bled to death. This event portrayed the severity and brutality of the way the Talibs acted. It also instilled fear in Amir right as he was about to go face the leader.
-
During the year after arriving back in the States, Sohrab has never spoken a word nor displayed any emotions. Miraculously, at a gathering of Afghans about a year later, Amir and Sohrab fly a kite together, and Sohrab had "one corner of his mouth...curled up just so. A smile" (Hosseini 370). This little hint of a smile is a major accomplishment in the relationship between Sohrab and Amir. It shows how he is starting to open up and be more comfortable around society and that there is still hope.
-
In September of 2005, the citizens are able to vote in their "first parliamentary elections in over 30 years," (BBC) and this is a major change for citizen rights.
-
Just as Afghanistan's economy is starting to reform itself again, "two former Kabul Bank chiefs, Sherkhan Farnood and Khalilullah Ferozi, are jailed for [a] multi-million dollar fraud" (BBC). This could have ended with many bigger consequences such as the fall of the entire country's banking system.
-
Two years ago in 2015, the "Taliban make bid to capture Sangin, a town and district in Helmand Province," but the "US warplanes deploy in support of Afghan security forces" (BBC). The Taliban's efforts in regaining dominance in their country are crushed.
Want to make a timeline like this?
Use Timetoast to turn dates, events, milestones, and phases into a clear visual timeline you can build and share. Timetoast is a timeline maker for work, school, research, and stories.